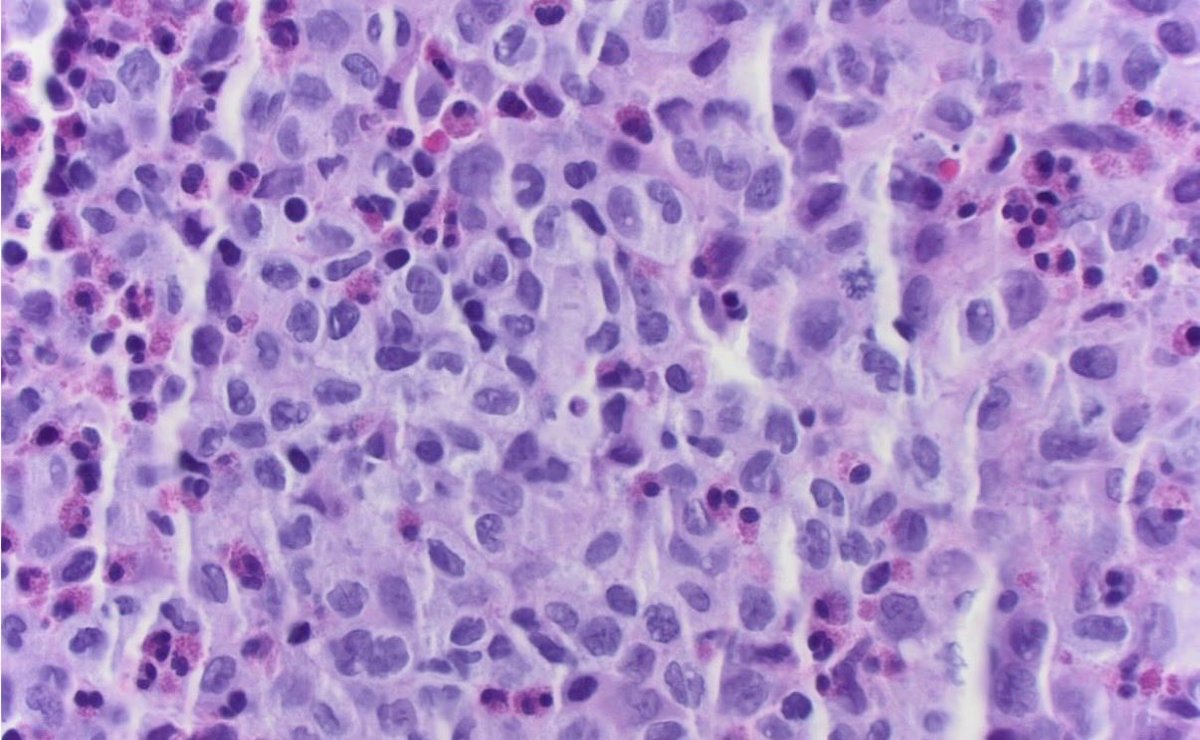
CUpathology tweet media

CUpathology
551 posts

CUpathology
@CU_pathology
The official twitter account of the University of Colorado Department of Pathology
Aurora, CO Beigetreten Aralık 2017
628 Folgt2.7K Follower

Happy Match Day! We are thrilled to welcome our incredible incoming class of residents.
Congratulations to everyone matching today! #Match2026 #PathMatch

English

Today!! Join us for a virtual first look at 5 pm MST! #pathmatch2026 #pathology #pathmatch @Path_SIG @MatchToPath

English

This will serve as a second Open House for those who were unable to join the first! Look forward to meeting you all! @Path_SIG @MatchToPath #pathology
#CUPathology #CUPath #Match2026 #OpenHouse #PathMatch
CUpathology@CU_pathology
Join us virtually September 16th from 5-7 PM MST to learn more about the University of Colorado and our amazing Pathology Residency Program! Links included below. 5-6 PM - GME Gneral Session: ucdenverdata.formstack.com/forms/cusom_fi… 6-7 PM - Pathology Breakout Session: ucdenver.zoom.us/j/92343204949
English

Join us virtually September 16th from 5-7 PM MST to learn more about the University of Colorado and our amazing Pathology Residency Program! Links included below.
5-6 PM - GME Gneral Session:
ucdenverdata.formstack.com/forms/cusom_fi…
6-7 PM - Pathology Breakout Session:
ucdenver.zoom.us/j/92343204949

English

Open House Today in just under two hours! See you there to tell you about CU path!
ucdenver.zoom.us/j/94862206505
CUpathology@CU_pathology
Come join us at our first Open House of the year on Sunday, August 17th! Excited to share the wonderful world of pathology and our amazing program! Sign up here: forms.cloud.microsoft/r/n7xLeEEYX8 #pathology #match2026 #pathmatch #pathtomatch #residency
English

We are thrilled to announce the availability of a PGY2 position at our program! PGY2s (or above) interested in transferring from their ACME accredited APCP program can reach out to Lindsey.westbrook@cuanschutz.edu and Francina.jeelani@cuanschutz.edu to apply! #pathologyresidency
English

Come join us at our first Open House of the year on Sunday, August 17th! Excited to share the wonderful world of pathology and our amazing program! Sign up here: forms.cloud.microsoft/r/n7xLeEEYX8
#pathology #match2026 #pathmatch #pathtomatch #residency

English
CUpathology retweetet

What is appendicitis? What does it look like under the microscope? Find out in this YouTube recording of #PediPathBasics
#PediPath
youtu.be/Zwd6cgHpb-Y?si…

YouTube

English
CUpathology retweetet

Our recent publication looking at IDH mutant gliomas in older adults. Thank you, @ZSiddiq00 for the survival analysis. Next we’ll look at US vs LMIC differences in survival in >55 yrs @AKUGlobal. @neuropathology @CU_pathology



English

We are thrilled to welcome our stellar class of incoming PGY1 residents!
Congratulations to everyone matching today. #pathmatch2025 #pathology

English
CUpathology retweetet

Happy Match Day! We are excited to meet the next class of pathology residents! #MatchDay2025 #PathMatch

English

ASMR for Pathologists
#pathology #asmr #satisfying #path #residency #laboratorymedicine #match2025 #pathologyoutlines #pathmatch25
Română
CUpathology retweetet

Endocrine Research Conference: Dr Dara Aisner and Dr Amy Guimaraes-Young presented on the amazing work from the molecular core facility. Molecular analysis of tumors of all types from even the smallest tissue to help diagnosis and treatment. @CU_pathology

English

ERAS is officially open so programs can view applicants. To all who are applying in the upcoming match cycle, good luck!! #Match2025 #pathmatch #pathology #residency #PathTwitter

English